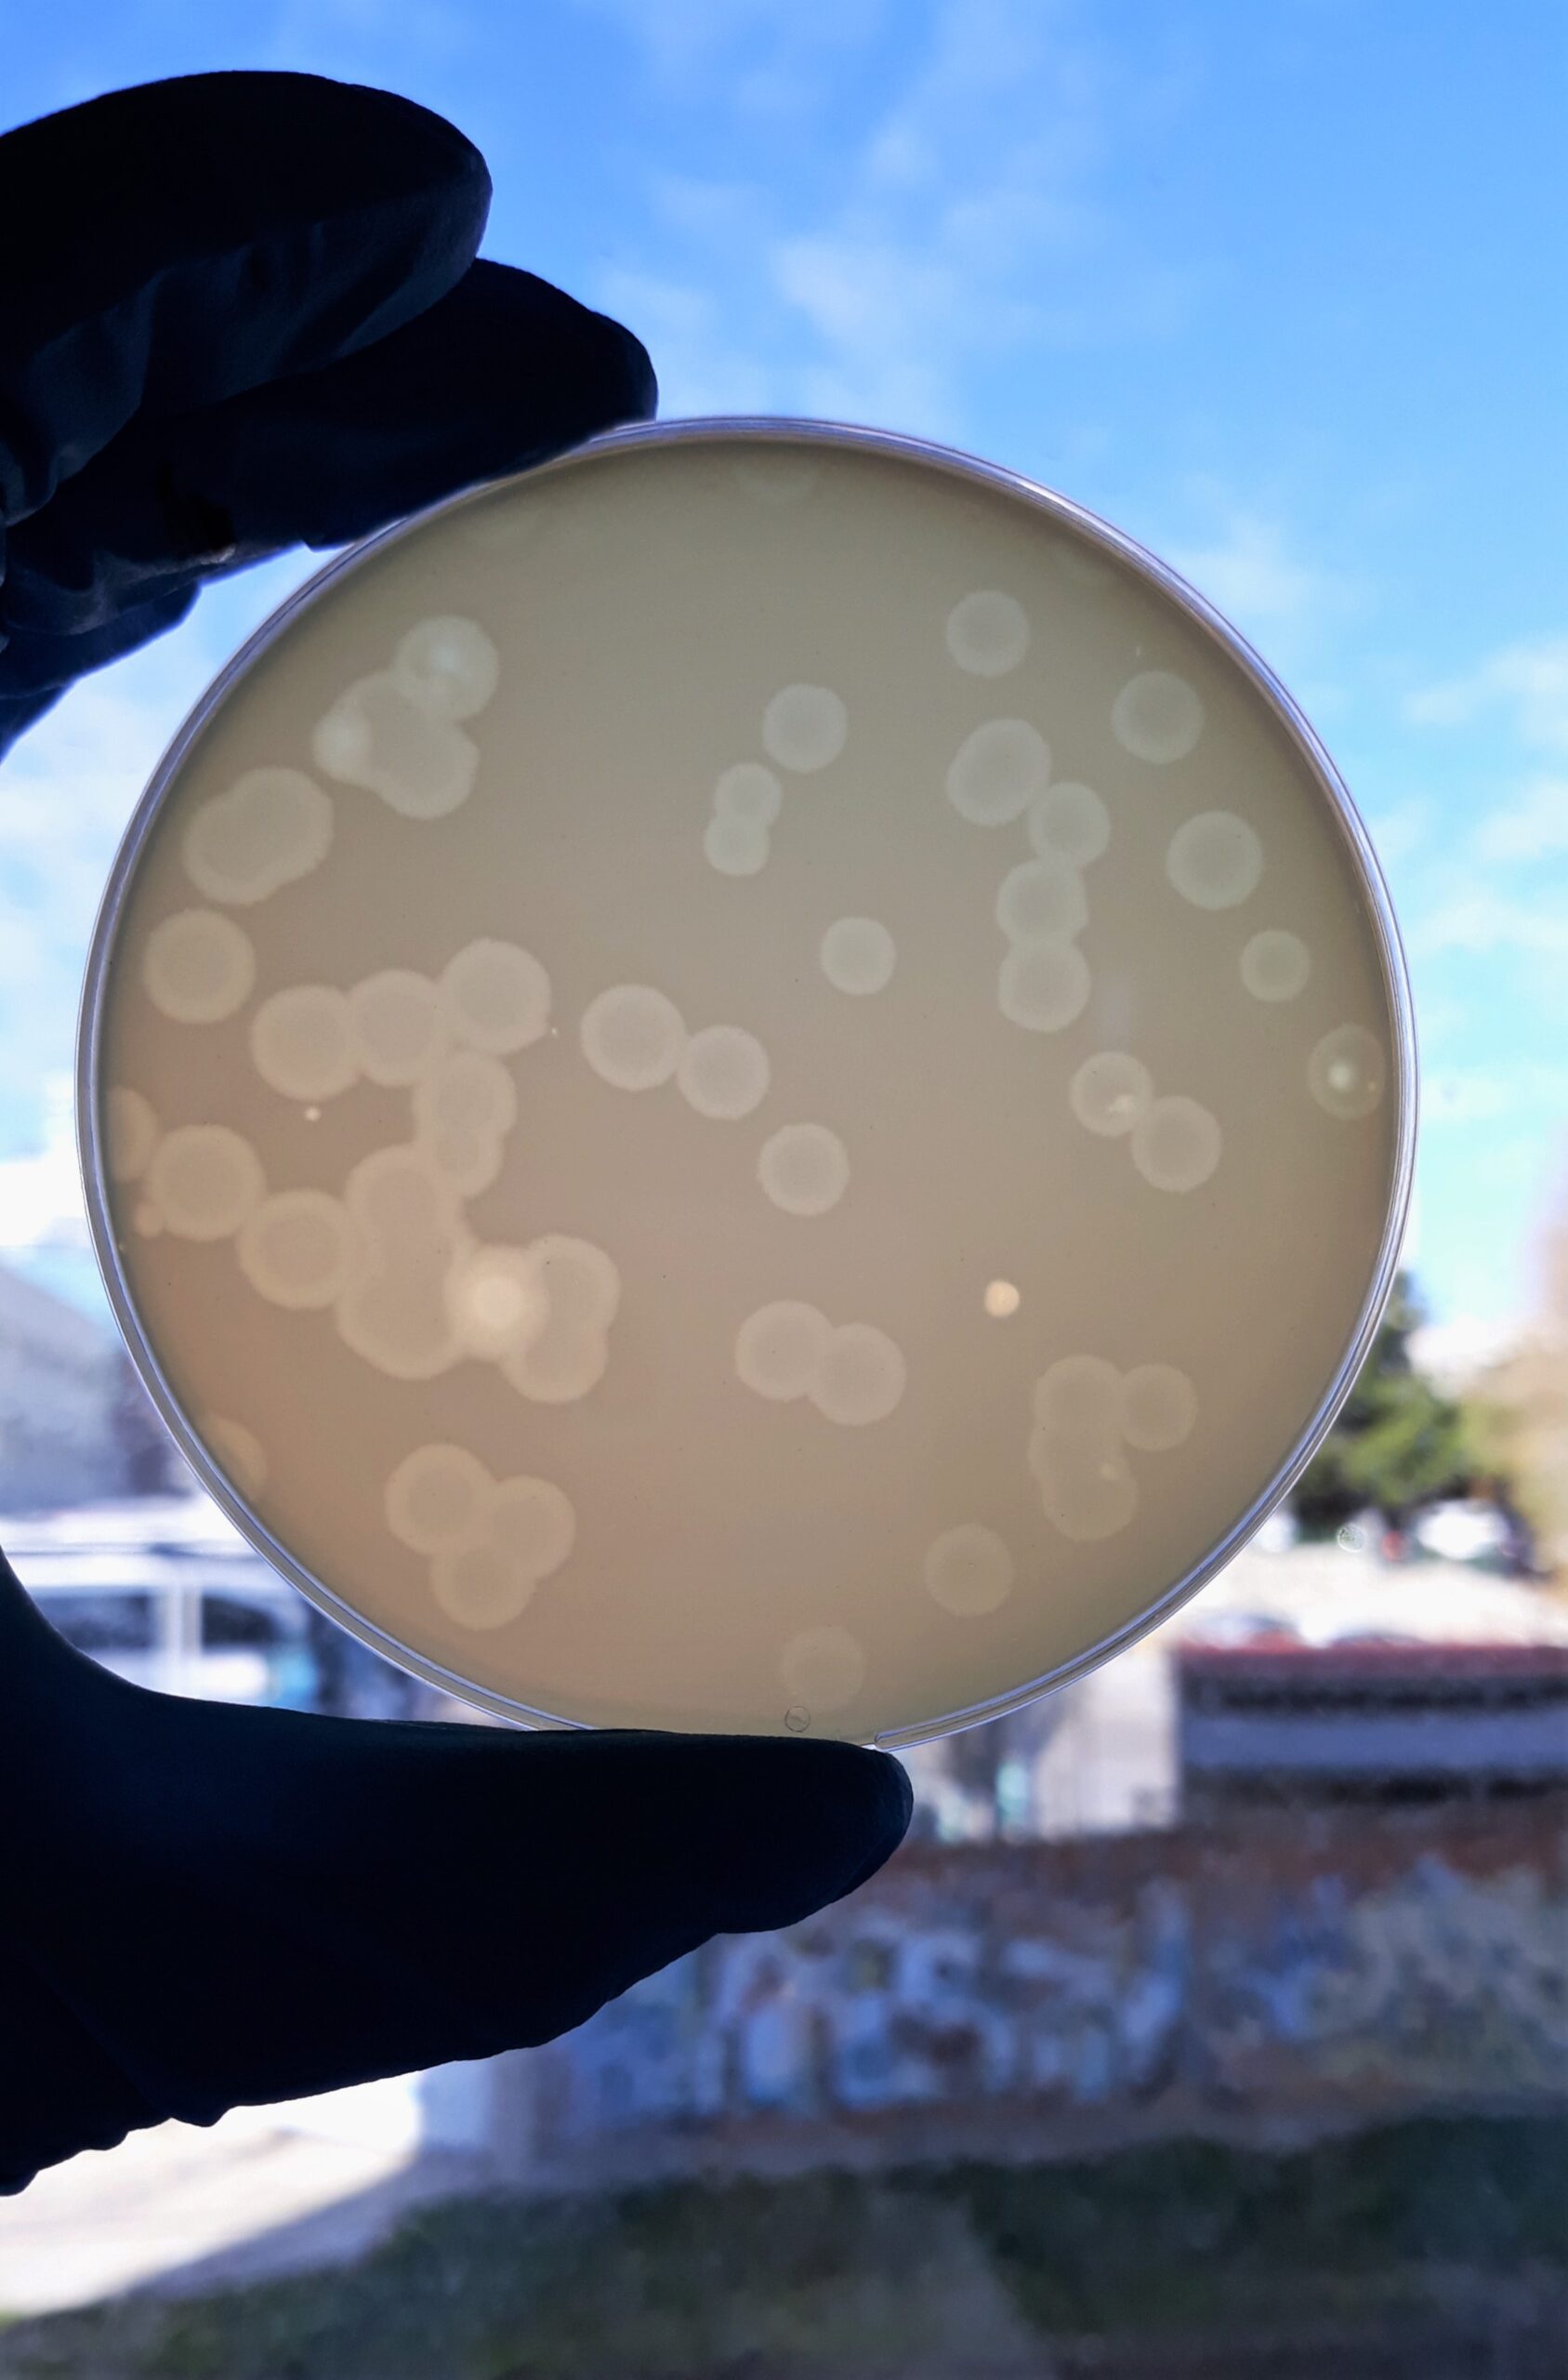

| 55 CEPAS CUANTITATIVAS en lentículas estabilizadas, 23.000 lentículas en stock para que Ud. no tenga que esperar, (REV: 30/09/2024) Y COLOR LENTÍCULA DEL LOTE / MEDIOS DONDE SE CONTROLA, RECOMENDACIONES… |
STOCK DISPONIBLE (u) |
MEDIA ± DESVIACIÓN UFC/LENTÍCULA |
DISPERSION DEL LOTE CV % |
USO PREFERENTE |
LOTE |
|
|
|
|
|
|
|
|
|
|
Blanco
para despistaje en intercomparativos y QCs, LOTES COLORES VARIOS |
1457 |
/// |
/// |
indefinido |
16-11-17 |
Acidolácticas Salvajes MIX2:
Bifidobacterium bifidum, Lactobacilus rhamnosus, L. helveticus LOTE COLOR VIOLETA MRS/CROMOKIT MRS, PASE 1 |
440 |
(1,6 ± 0,3) x 107 en MRS (4,56 ± 4,24) x 106 en MRS cromogénico |
13,11% en MRS 58,62 % en MRS cromogénico |
30-03-25 |
30-03-23 |
Aerobios heterotrofos MIX
ISO 11133 con Bacillus subtilis, Enterococcus faecalis, St.aureus, E.coli y Pseudomonas aeruginosa, LOTE COLOR VIOLETA, PCA/YEA, PASE 2 DESDE COLECCIÓN TIPO ES |
400 |
(6,42 ± 2,58) x 107 en PCA (7,00 ± 1,30)x107 en YEA |
27,78% en PCA 11,92% en YEA |
20-04-25 |
20-04-23 |
Aerococcus viridans
coco ambiental, Cat -, Ox -, interferente de Enterococos, LOTE COLOR AMARILLO, TSA/SB, PASE 2 DESDE COLECCIÓN TIPO ES |
400 |
(5,48 ± 4,28) x 106 en TSA (4,22 ± 3,88) x106 en SB |
46,73 % en TSA 61,56 % en SB |
20-04-25 |
20-04-23 |
Aspergillus niger brasiliensis
Pharmacopea (Test de promoción de medios para recuentos en medicamentos no estériles. Test de esterilidad. CHALLENGE TEST, moho inocuo amarillo y negro) LOTE COLOR PARDO SDA/RB/RYM PASE 3 |
440 |
(1,26 ± 0,44) x 106 en SDA (1,24 ± 0,26) x106 en RB (1,36 ±0,64) x 10E6 en RYM |
19,18% en SDA 14,96% en RB 30,35% en RYM |
16-05-26 |
16-05-24 |
Bacillus cereus,
MKTN 10320, COLOR VERDE PASE 3, Mossel/XBC |
440 |
(4,16 ± 1,54) x 104 en Mossel (2,70 ± 1,80) x 104 en XBC |
21,85% en Mossel 35,45% en XBC |
16-05-26 |
16-05-24 |
Bacillus subtilis subsp. spizizenii
Pharmacopea (Test de promoción de medios para recuentos en medicamentos no estériles. Test de esterilidad) PASE 3, COLOR VIOLETA TSA/PCA. Excelente para usar en el recuento de aerobios |
440 |
(4,64 ± 1,66) x 102 en TSA (4,42 ± 3,32) x 102 en PCA |
21,01% en TSA 52,95% en PCA |
13-06-25 |
13-06-23 |
Bacillus subtilis subsp. spizizenii
Pharmacopea (Test de promoción de medios para recuentos en medicamentos no estériles. Test de esterilidad) PASE 3, COLOR VIOLETA TSA/PCA. Excelente para usar en el recuento de aerobios |
0 |
[ALTA] |
|
31-10-26 |
31-10-24 |
Burkholderia cepacia
(Challenge Test ISO 11930, Pharmacopea 2019) Riesgo Gr.2 LOTE COLOR AMARILLO PASE 3, Equivale a NCTC 10473, TSA/BCPT crom/BCSA |
440 |
(4,46 ± 2,36) x 108 en TSA (6,24 ± 3,14) x 108 en BCPT-crom (5,92 ± 2,18) x 107 en BCSA |
34,11% en TSA 36,83% en BCPT-Crom 29,58% en BCSA |
23-07-26 |
23-07-24 |
Burkholderia cepacia
Riesgo Gr.2 LOTE COLOR VINO TINTO PASE 3, TSA/BCPT. Olor característico, desagradable. |
440 |
(2,00 ± 1,70) x 107 en TSA (1,64 ± 0,44) x 107 en BCPT |
46,90% en TSA 19,89 % en BCPT |
16-05-26 |
16-05-24 |
Campylobacter jejuni
|
0 |
|
|
XI/2026 |
XI/2024 |
Candida albicans
Pharmacopea (Test de promoción de medios para microorganismos específicos y recuentos en medicamentos no estériles. Test de esterilidad. Challenge Test ISO 11930) Riesgo Gr.2 PASE 3, LOTE COLOR AMARILLO PDA/Biggy. Excelente para usar en el recuento de aerobios y de hongos |
440 |
(4,86 ± 1,66) x 107 en PDA (3,04 ± 3,16) x 107 en Biggy |
22,86 % en PDA 64,82% en Biggy |
30-03-25 |
30-03-23 |
Candida albicans
Pharmacopea (Test de promoción de medios para microorganismos específicos y recuentos en medicamentos no estériles. Test de esterilidad. Challenge Test ISO 11930) Riesgo Gr.2 PASE 3, LOTE COLOR AMARILLO PDA/Biggy. Excelente para usar en el recuento de aerobios y de hongos |
0 |
|
|
XI/2026 |
XI/2024 |
Chryseobacterium indologenes
(Flavobacterium aureum) AEROBIO SALVAJE, de aguas ultrapurificadas de Lab.farmacéutico Riesgo Gr.2, LOTE COLOR NARANJA, PASE 1, TSA-Colonias naranjas/R2A colonias crema |
440 |
(3,10 ± 0,70) x 105 en TSA (5,66 ± 1,76) x 105 en R2A |
16,45% en TSA 18,92% en R2A |
16-05-26 |
16-05-24 |
Citrobacter freundii
MKTA 43864 (enterobacteria + y coliforme +, suele ser indol +) Fucsia en CCA, PASE 3, LOTE COLOR SANDIA TSA/CCA |
440 |
(1,18 ± 0,18) x 109 en TSA (5,9 ± 4,10) x 108 en CCA |
9,88% en TSA 42,03% en CCA |
30-03-25 |
30-03-23 |
Citrobacter freundii
MKTA 43864 (enterobacteria + y coliforme +, suele ser indol +) Fucsia en CCA, PASE 3, LOTE COLOR SANDIA TSA/CCA |
0 |
|
|
XI-26 |
XI/24 |
Clostridium bifermentans
(Paraclostridium) ISO 11133-2 (Desde FTM enriquecido, desecado en anaerobiosis doble para mejor mantenimiento) LOTE COLOR CARAMELO, TSC/Schaedler Agar, PASE 2 desde colección TIPO ES |
400 |
(2,66 ± 1,06) x 105 en TSC (1,70 ± 1,80) x 105 en Schaedler |
25,89% en TSC 55,80% en Schaedler |
20-04-25 |
20-04-23 |
Clostridium bifermentans
(Paraclostridium) ISO 11133-2 (Desde FTM enriquecido, desecado en anaerobiosis doble para mejor mantenimiento) LOTE COLOR CARAMELO, TSC/Schaedler Agar, PASE 2 desde colección TIPO ES |
0 |
|
|
XI-26 |
XI/24 |
Clostridium perfringens
ISO 11133-2 (Desde Cromokit-CP, desecado en anaerobiosis doble para mejor mantenimiento) LOTE COLOR SALMÓN TSC/Cromokit-CP Agar, PASE 3 |
440 |
(6,82 ± 2,02) x 104 en TSC (2,06 ± 1,24) x 104 en Cromokit-CP |
15,53 % en TSC 41,37% enCromokit-CP |
14-09-25 |
14-09-23 |
Clostridium perfringens
HEMOLÍTICO ISO 11133-2 (Desde FTM enriquecido, desecado en anaerobiosis doble para mejor mantenimiento) LOTE COLOR NEGRO, TSC/Cromokit-CP Agar, PASE 2 desde colección TIPO ES |
440 |
(3,82 ± 2,08) x 104 en TSC (5,48 ± 1,12) x 104 en Cromokit-CP |
29,87% en TSC 12,18% en Cromokit-CP |
05-10-25 |
05-10-23 |
Cutibacterium acnes ssp.acne
(Corynebacterium, Propionibacterium) CHALLENGE TEST ISO 11930, Riesgo Gr.2, Bacilo Gram positivo, anaerobio, saprófito de la piel humana, generador del acné, estudios forenses, LOTE COLOR PASE 1, Schaedler con 5% glicerol en anaerobiosis, 5-10 días |
0 |
[ALTA] |
|
31-10-26 |
31-10-24 |
Enterobacter aerogenes
(colonias rosa tenue en CCA) ISO 11133-2 LOTE COLOR SANDÍA. TSA/CCA. PASE 2 DESDE COLECCIÓN TIPO |
440 |
(1,18 ± 0,18) x 108 en TSA (1,02 ± 0,22) x 108 en CCA |
8,30% en TSA 15,69% en CCA |
05-10-25 |
05-10-23 |
Enterococcus faecalis
ISO 11133-2 PASE 2, LOTE COLOR NEGRO TSA/SB/BEA. Excelente para usar en el recuento de aerobios |
440 |
(2,70 ± 2,50) x 105 en TSA (1,76 ± 0,76) x 105 en SB (1,48 ± 1,22) x 105 en BEA |
49,41% en TSA 40,27% en SB 22,37% en BEA |
30-03-25 |
30-03-23 |
Enterococcus faecalis
ISO 11133-2 PASE 2, LOTE COLOR NEGRO TSA/SB/BEA. Excelente para usar en el recuento de aerobios |
0 |
|
|
31-10-26 |
31-10-24 |
Enterococcus faecium
ISO 11133-2 PASE 2, LOTE COLOR LILA-GRIS TSA/SB/BEA |
440 |
(3,32 ± 1,48) x 103 en TSA (2,8 ± 2,3) x 102 en SB (1,54 ± 0,54) x 103 en BEA |
25,23% en TSA 60,02% en SB 20,78% en BEA |
13-06-25 |
13-06-23 |
Escherichia coli
25922 LOTE COLOR AZUL PASE 2, TSA/MacConkey Agar, Equivale a NCTC 12241. Cepa lábil, por eso solo tiene 1 año de caducidad. |
380 |
(4,92 ± 1,42) x 105 en TSA (1,80 ± 1,70) x 105 en McConkey Agar |
16,98% en TSA 50,06% en McC |
18-01-25 |
18-01-24 |
Escherichia coli
25922 LOTE COLOR ROJO, PASE 2, TSA/CCA-MugPlus/MacConkey Agar, Equivale a NCTC 12241. Cepa lábil, por eso solo tiene 1 año de caducidad. |
440 |
(2,48 ± 1,38) x 107 en TSA (4,40 ± 2,90) x 106 en CCA (3,42 ± 3,98) x 106 en Mac Conkey Agar |
37,69% en TSA 41,39% en CCA 62,37% en McConkey |
23-07-25 |
|
Escherichia coli
25922 |
DADA LA LABILIDAD DE ESTA CEPA 25922, INDICAMOS 1 AÑO DE USO PREFERENTE, EN LUGAR DE DOS |
Escherichia coli
Pharmacopea (Test de promoción de medios para microorganismos específicos en medicamentos no estériles; y Challenge Test ISO 11930) Cepa MUG-, XGal +, XGlu+. Riesgo Gr.2 LOTE COLOR GRIS-BEIGE TSA/CCA PASE 3. No válida para los medios P/A |
440 |
(3,42 ± 1,12) x 107 en TSA (2,28 ± 1,72) x 106 en CCA |
16,48% en TSA 40,14 % en CCA |
05-10-25 |
05-10-23 |
Escherichia coli
Pharmacopea (Test de promoción de medios para microorganismos específicos en medicamentos no estériles; y Challenge Test ISO 11930) Cepa MUG-, XGal +, XGlu+. Riesgo Gr.2 LOTE COLOR VIOLETA, TSA/MacConkey PASE 3. No válida para los medios P/A |
440 |
(1,72 ± 0,32) x 107 en TSA (4,80 ± 3,60) x 106 en McC |
13,46% en TSA 45,93% en McC |
18-01-26 |
18-01-24 |
Escherichia coli
LOTE COLOR FUCSIA, PASE 2, TSA/CCA Colonias violeta oscuro. La cepa más recomendable de E.coli según nuestros intercomparativos SEILALIMENTOS. Citrato+ atípica. Funciona muy bien también en el recuento de aerobios. |
440 |
(2,32 ± 2,78) X 107 en TSA (1,98 ± 1,02) x 107 en CCA |
62,55% en TSA 32,17% en CCA |
13-06-25 |
13-06-23 |
Escherichia coli
ISO 11133-2, esta cepa crece con colonias azules en CCA pero a veces alguna colonia crece de color violeta: es XGlu/MUG variable. Según ISO es la misma ref USA de la cepa Pharmacopea WDCM00196. PASE 2, LOTE COLOR NARANJA TSA/CCA. No recomendable para los medios P/A |
440 |
,36 ± 0,44) x 104 en TSA (9,1 ± 4,0) x 103 en CCA |
23,98% en TSA 26,25% en CCA |
13-06-25 |
13-06-23 |
Escherichia coli
ISO 11133-2, esta cepa crece con colonias azules en CCA pero a veces alguna colonia crece de color violeta: es XGlu/MUG variable. Según ISO es la misma ref USA de la cepa Pharmacopea WDCM00196. PASE 2, LOTE COLOR NARANJA TSA/CCA. No recomendable para los medios P/A |
0 |
[ALTA] |
|
31-10-26 |
31-10-24 |
Escherichia coli
O157:H7 no-toxigénico. PASE 2 desde colección TIPO ES, LOTE COLOR NARANJA TSA/CCA MugPlus (colonias rojas pero indol +) |
400 |
(2,38 ± 0,42) x 108 en TSA (6,12 ± 3,52) x 107 en CCA |
10,08 % en TSA 45,72% en CCA |
20-04-25 |
20-04-23 |
Klebsiella oxytoca
(enterobacteria + y coliforme +, es Indol +) LOTE COLOR ROSA, PASE 3, TSA/CCA |
420 |
(7,68 ± 2,56) x 105 en TSA (2,78 ± 2,52) x 105 en CCA |
20,74% en TSA 52,94% en CCA |
18-01-26 |
18-01-24 |
Klebsiella pneumoniae
(=K.aerogenes, = K.variicola) ISO 11133-2 LOTE COLOR FUCSIA. TSA/CCA. PASE 2 DESDE COLECCIÓN TIPO. |
440 |
(2,18 ± 0,72) x 107 en TSA (1,68 ± 0,72) x 107 en CCA |
21,20% en TSA 27,51% en CCA |
05-10-25 |
05-10-23 |
Lactobacillus paracasei
probiótico vaginal salvaje LOTE COLOR AZUL ÍNDIGO PASE 2, MRS/CROMOKIT-Lactobacillus Agar. |
440 |
(5,36 ± 4,26) x 105 en Cromokit Lactobacillus Agar (6,82 ± 2,32) x 106 en TSA |
59,39% en CLA 19,70% en TSA |
09-03-25 |
09-03-23 |
Lactobacillus paracasei
probiótico vaginal salvaje LOTE COLOR AZUL ÍNDIGO PASE 2, MRS/CROMOKIT-Lactobacillus Agar. |
0 |
|
|
XI/26 |
XI/24 |
Listeria monocytogenes
SEROVAR 4B ISO 11133-2 PASE 3 LOTE COLOR VERDE LIMA TSA/O&A |
440 |
(1,52 ± 0,42) x 108 en TSA (1,30 ± 1,0) x 108 en O&A |
20,97 % en TSA 31,90% en O&A |
18-01-26 |
18-01-24 |
Listeria monocytogenes
SEROVAR 1/2a ISO 11133-2 PASE 2 desde colección TIPO ES, LOTE COLOR ESMERALDA, TSA/O&A |
400 |
(1,72 ± 2,10) x 106 en TSA (1,78 ± 1,22) x 105 en O&A |
47,86% en TSA 41,04% en O&A |
20-04-25 |
20-04-23 |
Listeria innocua
MKTN11288Z LOTE COLOR VERDE AZULADO PASE 1, TSA/O&A (Cromocytogenes Ottaviani & Agosti). Excelente para usar en el recuento de aerobios |
440 |
(1,42 ± 0,42) x 105 en TSA (1,46 ± 0,54) x 105 en O&A |
20,60% en TSA 23,17% en O&A |
05-10-25 |
05-10-23 |
Listeria ivanovii
(falso + de L.monocytogenes en Agar Ottaviani & Agosti) PASE 3, LOTE COLOR VERDE MENTA TSA/O&A |
440 |
(8,62 ± 0,98) x 107 en TSA (4,26 ± 3,84) x 107 en O&A |
8,69% en TSA 55,24% en O&A |
30-03-25 |
30-03-23 |
Listeria ivanovii
(falso + de L.monocytogenes en Agar Ottaviani & Agosti) PASE 3, LOTE COLOR VERDE MENTA TSA/O&A |
0 |
|
|
XI/26 |
XI/24 |
Pluralibacter gergoviae
Enterobacteria patógena en cosméticos Salvaje: procedente de champú con exceso de aerobios de la 1/2 N de España. LOTE COLOR PARDO. PASE 1, MUGPLUS/TSA. Color púrpura en MugPlus, colonias mucosas en TSA |
390 |
(3,50 ± 1,80) X 107 en TSA (4,40 ± 2,00) x 107 en MugPlus |
12,65% en TSA 25,59 % en MugPlus |
18-01-26 |
18-01-24 |
Proteus mirabilis
ISO 11133-2 LOTE COLOR GRIS-NEGRUZCO. TSA/ABC CROMOSALM. PASE 2 DESDE COLECCIÓN TIPO. Colonias muy mucosas. |
440 |
(1,52 ± 0,42) x 108 en TSA (1,20 ± 0,30) x 108 en ABC |
20,97% en TSA 17,48% en ABC |
05-10-25 |
05-10-23 |
Pseudomonas aeruginosa
ISO 11133-2 SUSTITUTO IDEAL DE LA lábil 26. Cepa longeva, lote con lentículas planas. LOTE COLOR LIMA TSA/Cetrimida Pase 2. Excelente también para usar en el recuento de aerobios. Pioverdina incluso desde TSA |
440 |
(1,34 ± 0,46) x 108 en TSA (1,22 ± 0,78) x 108 en Cet |
21,42% en TSA 41,28% en Cet |
13-06-25 |
13-06-23 |
Pseudomonas aeruginosa
9027 Pharmacopea (Test de promoción de medios para microorganismos específicos y recuentos en medicamentos no estériles. Test de esterilidad). CHALLENGE TEST, LOTE COLOR VERDE ESMERALDA TSA/Cetrimida. PASE 2 DESDE COLECCIÓN TIPO NCTC 12924. Pioverdina en CETRIMIDA. Olor típico a trapo sucio .Cepa lábil, por eso solo tiene 1 año de caducidad. |
400 |
(1,58 ±0,58) x 107 en TSA (1,84 ± 0,64) x 107 en Cetr |
28,13% en TSA 20,51% en Cetr |
18-01-25 |
18-01-24 |
Pseudomonas aeruginosa
9027 Pharmacopea (Test de promoción de medios para microorganismos específicos y recuentos en medicamentos no estériles. Test de esterilidad). CHALLENGE TEST, LOTE COLOR VERDE ESMERALDA TSA/Cetrimida. PASE 2 DESDE COLECCIÓN TIPO NCTC 12924. Pioverdina en CETRIMIDA. Olor típico a trapo sucio .Cepa lábil, por eso solo tiene 1 año de caducidad. |
0 |
|
|
31-10-25 |
|
Pseudomonas aeruginosa
9027 Pharmacopea (Test de promoción de medios para microorganismos específicos y recuentos en medicamentos no estériles. Test de esterilidad) CHALLENGE TEST |
DADA LA LABILIDAD DE ESTA CEPA 9027, INDICAMOS 1 AÑO DE USO PREFERENTE, EN LUGAR DE DOS |
Pseudomonas fluorescens
LOTE COLOR LIMA, TSA/KING B (crece mal en Cetrimida). PASE 2 DESDE COLECCIÓN TIPO ES. |
400 |
(1,52 ± 0,22) x 108 en TSA (1,88 ± 1,42) x 107 en King B |
9,67% en TSA 44,55% en King B |
20-04-25 |
20-04-23 |
Pseudomonas putida
CHALLENGE TEST ISO 11930. Riesgo Gr.2 Fluorescencia tenue. LOTE COLOR AMARILLO, PASE 2, TSA, Cetrimida. |
400 |
(1,62 ± 1,08) x 108 en TSA (5,04 ± 3,36) x 106 en CET |
41,21% en TSA 42,90% en CET |
09-07-26 |
09-07-24 |
Rhodotorula mucilaginosa
(levadura salvaje pigmentada de rojo, procede de ducha de agua de MadridI) LOTE COLOR NARANJA SDA/RB PASE 3. Excelente para usar en el recuento de aerobios |
440 |
(1,32 ± 0,32) x 107 en SDA (1,40 ± 0,40) x 107 en RB |
13,03% en SDA 16,90 % en RB |
18-01-26 |
18-01-24 |
Saccharomyces cerevisiae
(Pharmacopea ensayos de antibióticos, ISO 11133-2). LOTE COLOR MARRÓN Cepa lenta (6 días a 25ºC en Sabouraud SDA sin Caf, crece mejor en PDA), PASE 2, SDA/PDA |
440 |
(3,44 ± 1,66) x 106 en SDA (2,86 ± 1,84) x 106 en PDA |
28,10% en SDA 43,14% en PDA |
13-06-25 |
13-06-23 |
Salmonella enterica ssp. abony
Pharmacopea (Test de promoción de medios para microorganismos específicos en medicamentos no estériles) No suele comportarse como coliforme LOTE COLOR FRAMBUESA TSA/Cromosalm (DCA cromogénico, ABC ISO 6579), PASE 3 |
440 |
(3,14 ± 1,94)x106 en TSA (2,18 ± 2,22) x 105 en ABC |
35,21% en TSA 56,21% en ABC |
14-09-25 |
14-09-23 |
Salmonella enterica ssp. enterica
(S.enteritidis) No suele comportarse como coliforme LOTE COLOR VERDE LIMA TSA/Cromosalm (DCA Cromogénico, ABC ISO 6579), PASE 3 |
440 |
(7,12 ± 1,62) x 107 en TSA (3,02 ± 1,78) x 106 en ABC |
11,70% en TSA 35,99% en ABC |
14-09-25 |
14-09-23 |
Salmonella enterica typhimurium
Pharmacopea (Test de promoción de medios para microorganismos específicos en medicamentos no estériles) Suele comportarse como coliforme clásico (lactosa positivos) PASE 3, LOTE COLOR CORAL, TSA/XLD |
440 |
(1,36 ± 0,54) x 105 en TSA (1,22 ± 0,28) x 105 en XLD |
23,53% en TSA 16,72% en XLD |
30-03-25 |
30-03-23 |
Salmonella enterica typhimurium
Pharmacopea (Test de promoción de medios para microorganismos específicos en medicamentos no estériles) Suele comportarse como coliforme clásico (lactosa positivos) PASE 3, LOTE COLOR CORAL, TSA/XLD |
0 |
|
|
31-10-26 |
31-10-24 |
Serratia marcescens
crece mejor 48-72h a 25ºC, LOTE COLOR ROJO CORAL TSA/CCA PASE 3 |
440 |
(3,46 ± 1,24) x 106 en TSA (2,34 ± 0,54) x 106 en CCA |
26,53 % en TSA 15,19 % en CCA |
09-03-25 |
09-03-23 |
Shigella flexneri
SALVAJE LOTE COLOR VERDE PISTACHO, TSA/CCA PASE 3 |
420 |
(1,50 ± 0,30) x 107 en TSA (4,58 ± 1,62) x 106 en MugPlus |
12,65% en TSA 21,01% en MugPlus |
18-01-26 |
18-01-24 |
Staphylococcus aureus
ISO 11133-2 LOTE COLOR VERDE ESMERALDA TSA/BP. PASE 1 DESDE COLECCIÓN TIPO E. Colonias violetas y azul oscuro en BPX19 Agar |
440 |
(1,44 ± 0,76) x 107 en TSA (5,50 ± 2,20) x 106 en BP |
28,33% en TSA 24,53% en BP |
09-03-25 |
09-03-23 |
Staphylococcus aureus
ISO 11133-2 LOTE COLOR VERDE ESMERALDA TSA/BP. PASE 1 DESDE COLECCIÓN TIPO E. Colonias violetas y azul oscuro en BPX19 Agar |
0 |
|
|
31-10-26 |
31-10-24 |
Staphylococcus aureus
LOTE COLOR VERDE OLIVA, TSA/BP PASE 1 DESDE COLECCIÓN TIPO. Crece muy escaso en Mannitol, mucho mejor en BP y muy bien en TSA. Colonias lilas y gris-azuladas en BPX19 Agar |
440 |
(5,48 ± 2,02) x 108 en TSA (2,58 ± 2,22) x108 en BP |
20,23% en TSA 54,67% en BP |
13-06-25 |
13-06-23 |
Staphylococcus aureus
Pharmacopea (Test de promoción de medios para microorganismos específicos y recuentos en medicamentos no estériles. Test de esterilidad. Challenge Test). LOTE COLOR GRIS. TSA/BP. PASE 2 DESDE COLECCIÓN TIPO ES. Puede contener acompañantes: Colonias verdes (interferentes) y violetas en BPX19 Agar. |
440 |
(5,74 ± 2,74) x 103 en TSA (6,38 ± 1,92) x 103 en BP |
29,47% en TSA 23,15% en BP |
14-09-25 |
14-09-23 |
Staphylococcus aureus
Pharmacopea (Test de promoción de medios para microorganismos específicos y recuentos en medicamentos no estériles. Test de esterilidad. Challenge Test). Riesgo Gr.2. LOTE COLOR VIOLETA, TSA/BP/BPX. PASE 2 DESDE COLECCIÓN TIPO ES. Puede contener acompañantes: Colonias verdes (interferentes) y violetas en BPX19 Agar. |
400 |
(3,10 ± 1,60) x 108 en TSA (2,80 ± 1,40) x 108 en BP (4,32 ± 3,08) x 106 en BPX19 |
27,45% en TSA 26,24% en BP 48,14% en BPX19 |
09-07-26 |
09-07-24 |
Staphylococcus epidermidis
LOTE COLOR MARRÓN. TSA/BP. PASE 2 DESDE COLECCIÓN TIPO ES. Excelente para usar en el recuento de aerobios |
440 |
(3,26 ± 1,26) x 103 en TSA (1,84 ± 0,74) x 103 en B P |
26,50% en TSA 25,16% en BP |
18-01-26 |
18-01-24 |
Staphylococcus saprophyticus
ISO 11133-2 LOTE COLOR AZUL. TSA/BP. PASE 2 DESDE COLECCIÓN TIPO. Cepa coagulasa negativa, colonias color crema en TSA. Excelente para usar en el recuento de aerobios y como interferente de S.aureus |
440 |
(3,30 ± 0,90) x 107 en TSA (2,64 ± 0,76) x 107 en BP |
18,78 % en TSA 23,05 % en BP |
05-10-25 |
05-10-23 |
Yersinia enterocolitica
biotipo 1 serotipo 0:8, ISO 11133-2 LOTE COLOR FUCSIA, TSA/CCA MugPlus. PASE 2 DESDE COLECCIÓN TIPO ES. |
400 |
(4,60 ± 0,90) x 108 en TSA (3,44 ± 1,54) x 108 en CCA |
13,54 % en TSA 26,62 % en CCA |
20-04-25 |
20-04-23 |
Yersinia enterocolitica
biotipo 1 serotipo 0:8, ISO 11133-2 LOTE COLOR FUCSIA, TSA/CCA MugPlus. PASE 2 DESDE COLECCIÓN TIPO ES. |
0 |
|
|
XI/26 |
XI/24 |
Zygosaccharomyces rouxii
levadura Riesgo Gr.2. CHALLENGE TEST ISO 11930, alterativo de alimentos con elevada presión osmótica (azúcar, sal). LOTE COLOR PASE 1, SDA, MEA |
0 |
[ALTA] |
|
31-10-26 |
31-10-24 |
| TOTAL CEPAS CUANTITATIVAS |
23.347 |
|
|
|
|